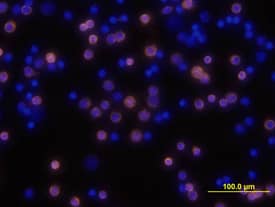
CD3 antibody in Mouse Splenocytes by Immunocytochemistry (ICC).

Mouse CD3 Biotinylated Antibody
R&D Systems, part of Bio-Techne | Catalog # BAM4841


Key Product Details
Species Reactivity
Validated:
Cited:
Applications
Validated:
Cited:
Label
Antibody Source
Product Specifications
Immunogen
Specificity
Clonality
Host
Isotype
Scientific Data Images for Mouse CD3 Biotinylated Antibody
Detection of CD3 in Mouse Splenocytes by Flow Cytometry.
Mouse splenocytes were stained with (A) Rat Anti-Mouse Biotinylated CD3 Monoclonal Antibody (Catalog # BAM4841) or (B) Rat IgG2B Biotinylated isotype control antibody (Catalog # IC013B) followed by Streptavidin-Phycoerythrin (Catalog # F0040) and Rat Anti-Mouse B220/CD45R APC-conjugated Monoclonal Antibody (Catalog # FAB1217A). View our protocol for Staining Membrane-associated Proteins.CD3 in Mouse Splenocytes.
CD3 was detected in immersion fixed mouse splenocytes using Rat Anti-Mouse CD3 Biotinylated Monoclonal Antibody (Catalog # BAM4841) at 10 µg/mL for 3 hours at room temperature. Cells were stained using the NorthernLights™ 557-conjugated Streptavidin (yellow; Catalog # NL999) and counterstained with DAPI (blue). View our protocol for Fluorescent ICC Staining of Non-adherent Cells.Applications for Mouse CD3 Biotinylated Antibody
Flow Cytometry
Sample: Mouse splenocytes
Immunocytochemistry
Sample: Immersion fixed mouse splenocytes
Immunohistochemistry
Immunoprecipitation
Reviewed Applications
Read 1 review rated 5 using BAM4841 in the following applications:
Formulation, Preparation, and Storage
Purification
Reconstitution
Formulation
Shipping
Stability & Storage
- 12 months from date of receipt, -20 to -70 °C as supplied.
- 1 month, 2 to 8 °C under sterile conditions after reconstitution.
- 6 months, -20 to -70 °C under sterile conditions after reconstitution.
Background: CD3
The T cell receptor (TCR)/CD3 complex consists of two variable antigen-recognition receptor chains (TCR-alpha/TCR-beta or TCR-gamma/TCR-delta) that are non-covalently linked to at least four different invariant chains: CD3 gamma, CD3 delta, CD3 epsilon, and the CD3 zeta chain that exists as either a homodimer or as a heterodimer with its splice-variant the CD3 eta chain. The CD3 complex functions to transduce intracellular signals during TCR antigen recognition. CD3 is expressed early in thymocyte development, and on a subset of NK cells. CD3 epsilon is one of at least three invariant proteins that associate with the variable antigen recognition chains of the T cell receptor and function in signal transduction.
References
- Miescher, G.C. et al. (1989) Immunol. Lett. 23:113.
Alternate Names
Gene Symbol
Additional CD3 Products
Product Documents for Mouse CD3 Biotinylated Antibody
Product Specific Notices for Mouse CD3 Biotinylated Antibody
For research use only